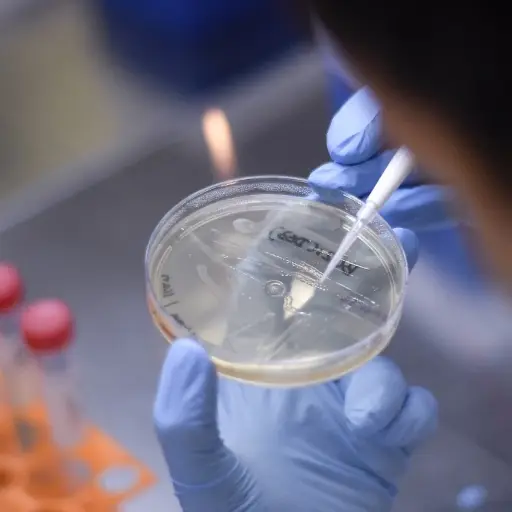
AFP

farmacéuticas
Nacionales
PGN pide diligencia al MP en caso de posible lavado de dinero
- por Eliseo de León
- 08:50 PM, Jul 21
Nacionales
COVID-19: Buscan que compra de vacunas se apruebe de urgencia
- por Jerson Ramos
- 10:18 AM, Ene 06
En Portada
Temas
×

¿Activar notificaciones?
Recibe las últimas novedades directamente en tu dispositivo.